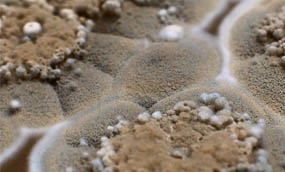

|
Избавиться от плесени в Златоусте
Плесень - это один из самых распространенных видов грибков, которые могут появляться в домах и других зданиях, причиняя различные проблемы, включая аллергии и проблемы с дыханием. Плесень может появляться в любом месте, где есть влажность и тепло, и может быть очень трудно избавиться от нее. В этой статье мы расскажем о профессиональной обработке от плесени в Златоусте.
Перед обработкой от плесени необходимо выяснить причину ее появления. Это может быть утечка кровли, поврежденные трубы или проблемы с вентиляцией. Если не устранить причину, плесень вернется снова и снова, даже после обработки.
Когда причина выяснена, можно приступать к обработке. В профессиональной дезинфекционной компании используются различные методы обработки, но одним из наиболее эффективных методов является обработка плесенецида.
Плесенецид - это препарат, специально разработанный для уничтожения плесени и других видов грибков. Он содержит химические вещества, которые эффективно убивают грибки и помогают предотвратить их повторное появление. Обработка плесенецидом может производиться как внутри помещения, так и снаружи.
Перед обработкой помещения от плесени специалисты проводят диагностику, чтобы выяснить уровень заражения и наличие потенциально опасных участков. В зависимости от этого подбирается оптимальный метод обработки.
Обычно специалисты используют холодное и горячее туманообразование. Холодное туманообразование - это метод, при котором специальное оборудование создает туман из плесенецида, который затем распыляется по всему помещению. Этот метод особенно эффективен, когда плесень располагается на труднодоступных местах, таких как вентиляционные шахты и дренажные трубы.
Важным моментом при борьбе с плесенью является предотвращение ее повторного появления. Для этого необходимо следить за уровнем влажности в помещении, проводить регулярную вентиляцию, а также устранять источники утечек и протечек воды.
Однако, если плесень уже присутствует в помещении, то для ее устранения применяются различные методы обработки. Один из таких методов - это обработка специальными растворами, которые наносятся на поверхность с плесенью и удаляют ее. Однако, при этом существует риск повреждения поверхности, на которой происходит обработка.
Более эффективным и безопасным методом обработки от плесени является применение химической обработки с использованием низкотоксичных препаратов. Этот метод позволяет быстро и эффективно устранить плесень без повреждения поверхности. Однако, применение химических растворов может быть опасно для здоровья, поэтому необходимо использовать защитную экипировку и строго соблюдать инструкции по применению.
Еще одним методом обработки от плесени является применение ультрафиолетовых ламп, которые удаляют плесень при помощи ультрафиолетовых лучей. Этот метод также является эффективным и безопасным для здоровья, однако требует специального оборудования и квалифицированных специалистов для его проведения.
В любом случае, выбор метода обработки от плесени в Златоусте зависит от степени поражения помещения и материалов, из которых оно сделано. Поэтому рекомендуется обратиться за консультацией к специалистам в области дезинсекции и дезинфекции для выбора наиболее эффективного и безопасного метода.
|